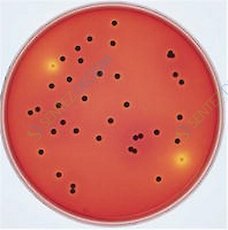
MERCK 113919.0500 Xlt4 Agar (Base) For Microbiology

2.000 TL ve üzeri alışverişlerinizde Kargo ÜCRETSİZ!
+300.000'den fazla ürünü sizlerle buluşturuyoruz...
Türkçe
- Ansayfa
- Kategoriler Kategoriler
- Genel
- Laboratuvar Cihazları Laboratuvar Cihazları
- Sıvı Aktarım Cihazları Sıvı Aktarım Cihazları
- Santrifüjler
- Çeker Ocak Çeker Ocak
- Saf Su Cihazları Saf Su Cihazları
- Manyetik Karıştırıcılar Manyetik Karıştırıcılar
- Kül Fırını
- Teraziler
- Nem Tayin Cihazları
- Viskozimetreler
- Homojenizatör
- Ph Metreler
- Mekanik Karıştırıcılar Mekanik Karıştırıcılar
- Su Analiz Cihazları
- Pompalar
- Çalkalayıcılar
- Refraktometreler Refraktometreler
- Ultrasonik Banyolar Ultrasonik Banyolar
- Otoklavlar
- Isıtıcı Tablalar
- İklimlendirme Kabini
- Spektrofotometre Spektrofotometre
- Mikroskoplar
- Tekstil Cihazları
- Vorteks
- Etüv | İnkübatörler
- Liyofilizatörler
- İletkenlik Ölçüm Cihazları
- Sanayi Ölçüm Cihazları
- Rotary Evaporatör
- Maden Cihazları Maden Cihazları
- Kırıcı | Öğütücü | Parçalayıcı Kırıcı | Öğütücü | Parçalayıcı
- Laboratuvar Değirmeni
- Marcy Density Meter
- Elek Sallama Cihazı Elek Sallama Cihazı
- Bakır Miktarı Tayini Cihazı Bakır Miktarı Tayini Cihazı
- Kırıcı | Öğütücü | Parçalayıcı
- Gıda Cihazları
- Hijyen ve Hava Monitörü
- Kyroskop-donma Noktası Tespit
- Erime Noktası Tayin Cihazı
- Soxhlet Yağ Analiz Cihazı
- Karbon Kükürt Tayin Cihazı
- Mantolu Isıtıcılar
- Soğutmalı İnkübatörler
- Jar Test
- Mikrobiyoloji Cihazları
- Kuru Blok Isıtıcıları
- Sıvı Aktarım Cihazları
- Cam Malzemeleri Cam Malzemeleri
- Balon Balon
- Balonjoje Balonjoje
- Beher
- Desikatör
- Erlen
- Huni
- Lam-lamel-şale Lam-lamel-şale
- Adaptörler
- Alkolmetre
- Alonj
- Baget
- Büret
- Dansimetre/bomemetre Dansimetre/bomemetre
- Havanlar Havanlar
- Kapaklar Kapaklar
- Karıştırıcı Şaftı Karıştırıcı Şaftı
- Kolon Kolon
- Cam Musluklu Cam Musluklu
- Teflon Musluklu Teflon Musluklu
- Vigreux Destilasyon Vigreux Destilasyon
- Cam Musluklu
- Kroze
- Mezür
- Büret Otomatik
- Petri Kabı Petri Kabı
- Piknometre
- Pipet Pipet
- Reaksiyon Kabı Reaksiyon Kabı
- Saat Camı
- Soğutucular
- Termometreler Termometreler
- Tüpler Tüpler
- Kapiler Tüp
- Deney Tüpü
- Tüp - Vidalı Kapaklı
- Gaz Ölçme Tüpü
- Geisler Tüpleri
- Katot Işınları Tüpü
- Serbest Düşme Tüpü
- Petrol Test Tüpü
- Fermentasyon Tüpü
- Gardner Tüpü
- Folin Tüpü
- Esbah Tüpü
- Nesler Tüpü
- Erime Noktası Tayini
- Yakma Tüpü
- Durham Tüpü
- Kurutma Tüpü
- Ksilol Cihazı Tüpü
- Tüp Durhaim
- Hematocrit Tüpü
- Nessler Tüpü
- Santrifüj
- vezin Kabı
- Vakum ve Süzme Setleri Vakum ve Süzme Setleri
- Tayin Düzeneği Tayin Düzeneği
- Ekstraktör Soxhlet
- Şişeler Şişeler
- Kristalizuar
- Musluk
- Başlık
- Küvet Küvet
- Vialler Vialler
- Kategorisiz
- Balon
- Sarf Malzemeler Sarf Malzemeler
- Plastik Malzemeler Plastik Malzemeler
- Genel Lab Sarf Malz. V.b.
- Etiketler Etiketler
- Alüminyum Malzemeler
- Tıpalar Tıpalar
- Hortum
- Metal Malzemeler
- Porselen Malzemeler
- Havanlar
- Ahşap Malzemeler
- Pastör Pipet
- Tekstil Sarf Tekstil Sarf
- Filtrasyon
- Kromotografi Malzemeleri
- Temizlik
- Şırınga Ucu Filtreleri
- Tartım Kapları
- Numune Şişeleri
- Spatüller
- Puar | Pompalar
- Fırça | Maşalar
- Kroze | Kapsül | Kayıkçı
- Filtre Kağıtları
- Kartuşlar
- Piset ve Damlalıklar
- Tlc Plaka
- Manyetik Balık Manyetik Balık
- Büyüteçler
- Numune Alma Apartları
- Kronometre | Saatler | Pusula
- Plastik Malzemeler
- Kimyasallar Kimyasallar
- Tekkim Kimyasal ve Çözeltileri
- Çözeltiler ve Analiz Kitleri
- Sigma Aldrich Kimyasalları
- Merck Kimyasalları & Standartları & Kitleri
- Teknik Kimyasallar
- Renk Gidericiler
- Sigma Aldrcih Kimyasalları
- Isolab Kimyasalları
- Honeywell Kimyasalları
- Icp Standartları
- Carlo Erba Kimyasalları
- Carlo Erba Kimyasalları
- Afg Scientific Kimyasalları
- Teknik Kimyasallar
- Mikrobiyoloji
- Kimyasallar ve Çözeltiler Kimyasallar ve Çözeltiler
- Markalar Markalar
- Wei̇ghtlab
- Isolab
- Tekki̇m
- Elektro-Mag
- Norateks
- Pce Instruments
- Sdc
- Testfabrics
- James Heal
- Lamy Rheology
- Ohaus
- Presica
- Kern
- Funke Gerber
- Filter - Lab
- Wtw
- Radwag
- Dlab
- Ri̇gol
- Soif
- Bandelin
- Memmert
- Hermle
- Zealway
- Strike
- Viantech
- Stereglass
- Cls
- Hydraultrasonic
- Shenchen
- Faithful
- Kudos
- Equs
- Aivac
- Woosung
- Fuego
- Lauda
- Vacuubrand
- Tomy
- Mtops
- Jsr
- Si̇gma Aldrich
- Xs Instrumens
- Metler Toledo
- Shimadzu
- And
- Sentez Deği̇şi̇m
- Mari̇endfeld
- Thermo Fi̇sher
- IKA
- Binder
- Brand
- Vwr
- Sartori̇us
- Preci̇sa
- Eppendorf
- Rocker
- Ebro
- Vitlab
- Rainin
- Whatman
- Kartell Labware
- Carlo Erba
- Haldenwanger
- Chem Solute
- Borucam
- Velp
- Merck
- Brookfield
- Firat
- Labo
- Lp Italiana
- Nükleon
- Nüve
- Si Analiytics
- Testlab
- Testo
- Tfa
- Wiggens
- Greinorm
- Isotherm
- Llg
- Glassco
- Pantone
- Lamtek
- Inesa
- Viantech
- Ahl
- D+Z Ecoli̇ne
- Beyes
- İnod
- Osung
- K-Scope
- Xpedent
- D+Z
- Ava
- Biomta
- K-Clamp
- Ki̇ds Crown
- Perma Crown
- Deppeler
- Dochem
- Dental Studi̇o
- Honeywell
- Biosan
- Afg Scientific 213238-Abts
- Afg Scientific
- Mettler Toledo
- Joanlab
- Aqua-Boy
- Zag
- Serlab
- Sektörler
- Hakkımızda
- Bize Ulaşın